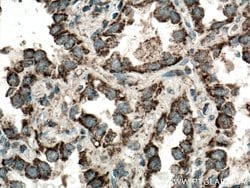
LONP1 Rabbit anti-Human, Mouse, Rat, Polyclonal, Proteintech 20 &mu;L | Buy Online | Proteintech | Fisher Scientific

missing translation for 'onlineSavingsMsg'
Learn More
Learn More
Description
This gene encodes a mitochondrial matrix protein that belongs to the Lon family of ATP-dependent proteases. This protein mediates the selective degradation of misfolded, unassembled or oxidatively damaged polypeptides in the mitochondrial matrix. It may also have a chaperone function in the assembly of inner membrane protein complexes, and participate in the regulation of mitochondrial gene expression and maintece of the integrity of the mitochondrial genome. Decreased expression of this gene has been noted in a patient with hereditary spastic paraplegia. Alternatively spliced transcript variants have been found for this gene.
Specifications
Specifications
| Antigen | LONP1 |
| Applications | Immunocytochemistry, Immunohistochemistry (Paraffin), Immunofluorescence, Western Blot, Immunoprecipitation |
| Classification | Polyclonal |
| Concentration | 0.33 mg/mL |
| Conjugate | Unconjugated |
| Formulation | PBS with 50% glycerol and 0.02% sodium azide; pH 7.3 |
| Gene | LONP1 |
| Gene Accession No. | P36776, Q8CGK3, Q924S5 |
| Gene Alias | hLON, LON, lon peptidase 1, mitochondrial, Lon protease like protein, LonHS, LONP, LONP1, PIM1, PRSS15, Serine protease 15 |
| Gene Symbols | Lonp1 |
| Show More |
Product Title
By clicking Submit, you acknowledge that you may be contacted by Fisher Scientific in regards to the feedback you have provided in this form. We will not share your information for any other purposes. All contact information provided shall also be maintained in accordance with our Privacy Policy.
Spot an opportunity for improvement?